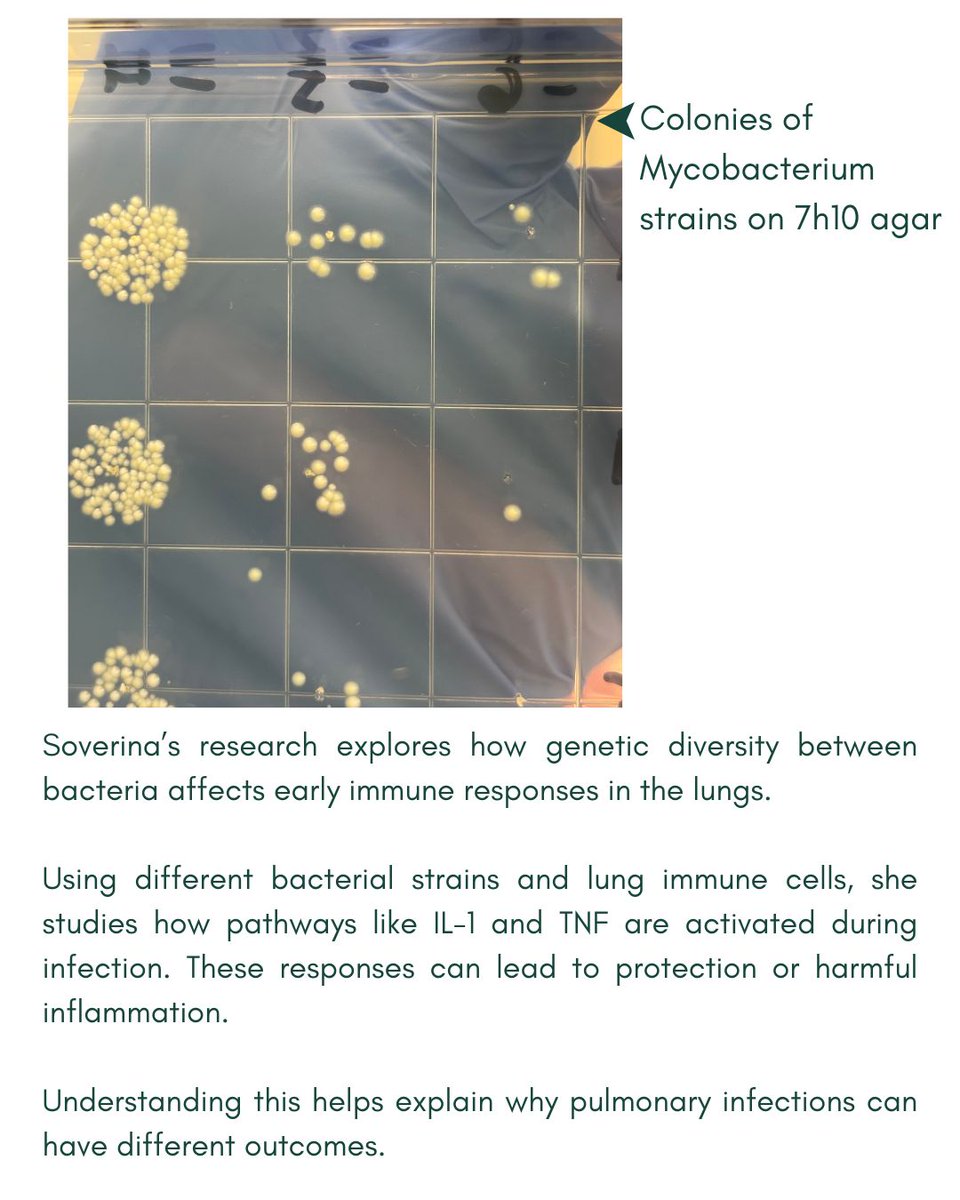
MSU Microbiology, Genetics, & Immunology tweet media
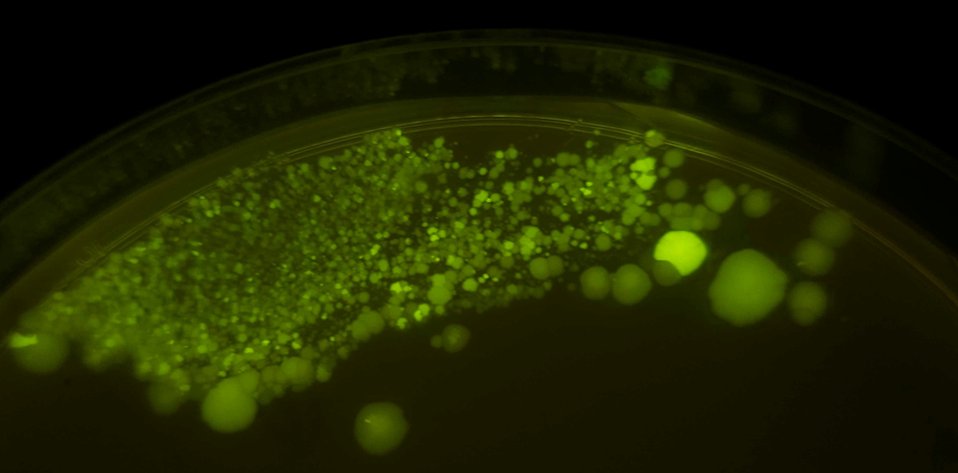
MSU Microbiology, Genetics, & Immunology tweet media

MSU Microbiology, Genetics, & Immunology retweetledi

“Project Hail Mary” is a great way to explore what life on other planets could look like beyond the Marvin the Martian stereotype.
@msumgi @eesmsu @msunews
What 'Project Hail Mary' gets right about microbes:
msunatsci.info/4lEaQtV
English